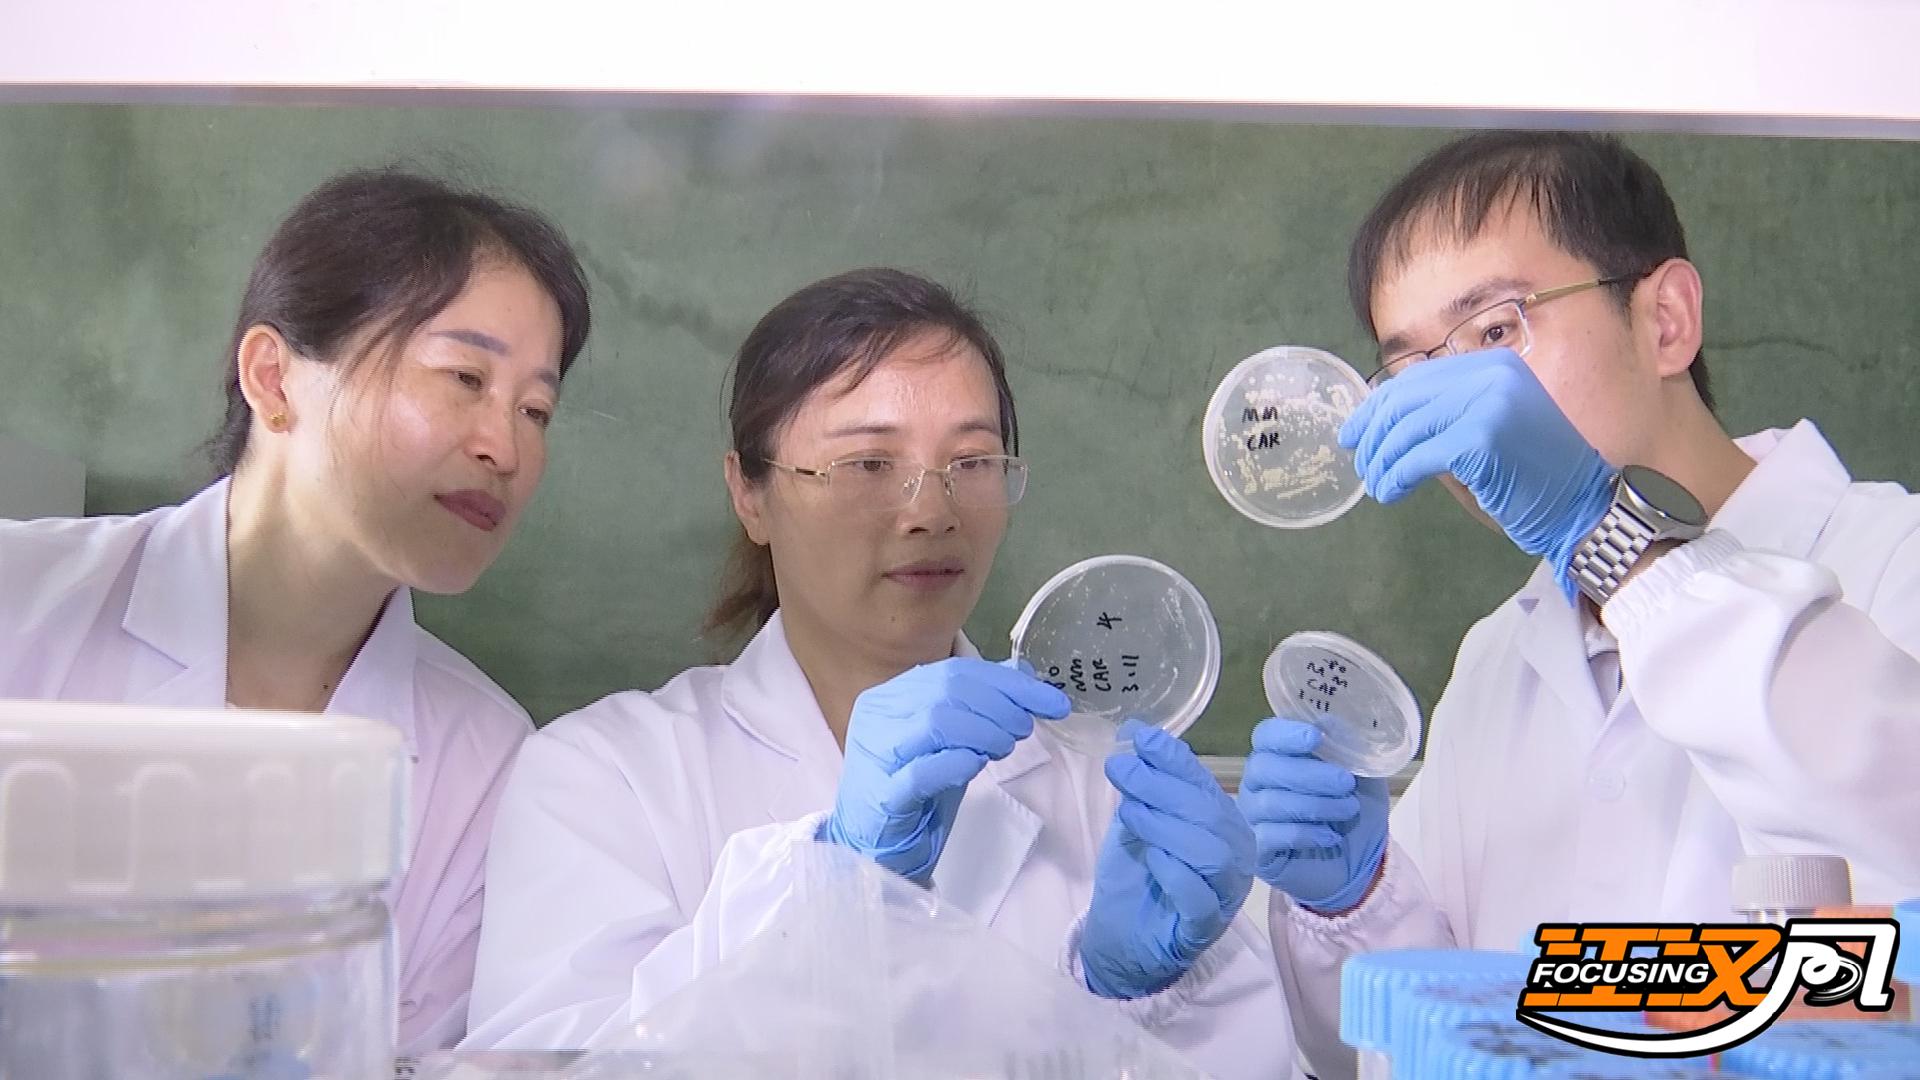

江汉风报道:中华鲟是长江水生生物保护的“旗舰”物种。作为中华鲟保护重镇,荆州拥有全国半数以上的子一代中华鲟,可以说是名副其实的“中华鲟宝宝”摇篮。为了让中华鲟宝宝健康成长,荆州率先成立中华鲟“专科医院”,还首次发现中华鲟疱疹病毒。

许巧情是长江大学动物科学技术学院教授,长期从事淡水鱼类疾病防治研究。在一次次学术交流会议中,许巧情发现中华鲟患病的案例越来越多,养殖机构、企业束手无策,损失惨重。2016年,许巧情发起成立长江大学中华鲟病害研究所,成为国内唯一的中华鲟病害专门防治机构。
长江大学动物科学技术学院教授、长江大学中华鲟病害研究所所长许巧情介绍:早期的时候鲟鱼很多都是野生的,野外的,那么它的亲本质量确实好一些。现在随着人工的养殖,子一代子二代都是人工养殖,长期就在室内环境养,它没有这种洄游的路线,所以造成了体质相对以前来说要弱得多。

许巧情介绍,每年12月至次年3月,中华鲟鱼苗出生不久,身体十分脆弱,水质、水温、细菌等因素,都可能引发病害。

长江大学动物科学技术学院教授、长江大学中华鲟病害研究所所长许巧情表示:因为刚繁殖出来的鱼苗,它的免疫力是非常低下的,应该是免疫系统没有发育成熟。尤其是免疫器官还是非常小,不完善。所以它的抵抗力非常弱,另外刚出来的苗会受当时的水环境影响,如果亲本的品质不是很高的时候会造成后代的抵抗力也弱。
万事开头难。没有中华鲟病害样本,许巧情便从其他鲟鱼寻求突破,从提高中华鲟免疫力开始做起。2021年,她和危起伟等专家合著《鲟免疫系统及病害防控》一书,专门介绍了中华鲟免疫系统研究成果。2021年11月,许巧情接到省内一家中华鲟养殖企业求助,该企业基地的1月龄幼鱼出现大量死亡。许巧情迅速带领团队前往检测,发现一种疱疹病毒。

长江大学动物科学技术学院教授、长江大学中华鲟病害研究所所长许巧情介绍:通过取样,然后送到公司做宏基因组的测序。同时对测序结果进行分析,之后从里面我们首次发现了鲟疱疹病毒1型,这是我们首次发现,以前没有见到过,这种病毒性的病对中华鲟幼鱼的感染率还是非常高的,当时发现1月龄的基本上死亡率达到80%以上。
这是国内第一次在中华鲟体内发现疱疹病毒,为后期开展中华鲟病害研究提供了新方向。

长江大学动物科学技术学院教授、长江大学中华鲟病害研究所所长许巧情:接下来我们会围绕这个疱疹病毒,包括中华鲟里面其它的病毒,进行深入研究,因为病毒疾病一旦感染了以后治愈率很低,很难治愈。我们会加强对它的研究,争取把它的疫苗做出来,疫苗有了以后会对鱼进行免疫注射,会起到预防疾病的作用。

成立8年来,长江大学中华鲟病害研究所研究范围扩展到水环境、营养、病害、疫苗等研究领域,累计培养30多名硕士研究生。长江大学被中华鲟保护联盟纳入成员单位。
长江大学动物科学技术学院教授、长江大学中华鲟病害研究所所长许巧情介绍:我们多次对国内相关的中华鲟病害进行检测,挽救了几百万尾中华鲟的鱼苗和成鱼。

眼下,许巧情团队正在开展中华鲟亲缘关系鉴定,可帮助养殖机构和企业避免中华鲟近亲繁殖,有效降低病害发生率。
(记者:卢艳、胡威虎、唐杰/编辑:王向明/一审:唐杰/二审:王桃芳/三审:江敏)

请输入验证码